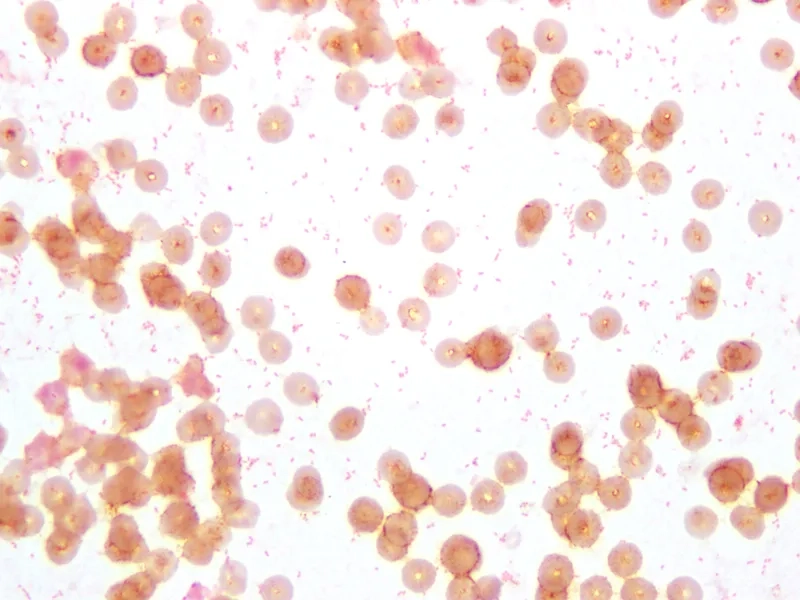
A diagram illustrating brucellosis transmission routes
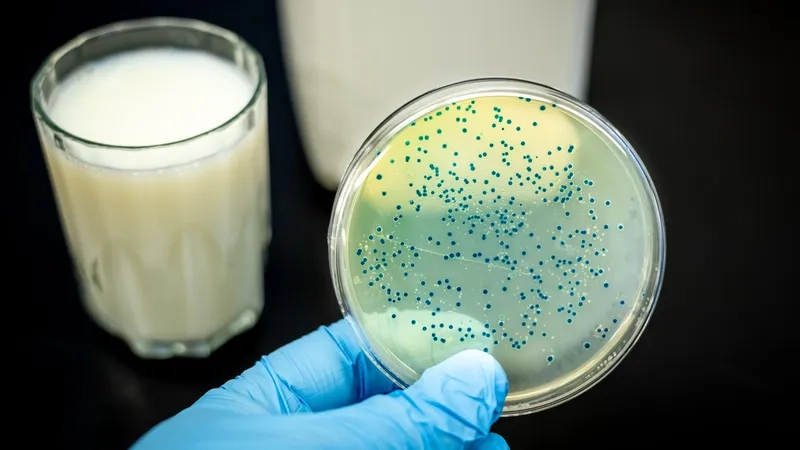
A guide to the standard treatment for brucellosis

Do you consume unpasteurized dairy or work with livestock? Understanding Brucellosis is not just academic—it's essential for your health. Don't risk a persistent fever; learn the facts now to protect yourself and your family from this serious infection.
What are the main causes of Brucellosis?
- The primary cause is infection with various strains of Brucella bacteria, which are typically found in animals like cattle, goats, sheep, and pigs.
- Brucellosis transmission to humans most commonly occurs through the consumption of unpasteurized dairy products, especially brucellosis from raw milk and soft cheeses.
- Direct contact with infected animal tissues or inhaling the bacteria also poses a significant risk, particularly for veterinarians, farmers, and slaughterhouse workers.

Key symptoms of Brucellosis to watch for
- A key indicator among brucellosis symptoms is a recurring or undulant fever that rises and falls over weeks, often accompanied by profuse night sweats.
- Patients frequently experience debilitating fatigue, headaches, severe joint and muscle pain, and a significant loss of appetite, which may lead to weight loss.
- If it develops into chronic brucellosis, the long-term effects of brucellosis can include arthritis, organ swelling, and persistent fatigue lasting for years.
How can you prevent Brucellosis effectively?
- The most crucial step on how to prevent brucellosis is to avoid all raw milk and unpasteurized dairy products; always choose pasteurized options.
- Individuals working with animals should wear protective gear like gloves and goggles and practice excellent personal hygiene to prevent exposure to infected tissues.
- Vaccinating livestock helps control brucellosis in animals, effectively reducing the primary source of the bacteria and protecting the human population.
>>> See more: Toxoplasmosis: Risks During Pregnancy and Prevention
Recognizing the warning signs of Brucellosis through images

>>> Learn now: West Nile Virus Infection: Symptoms and Prevention Tips
Brucellosis is a serious but treatable disease. An accurate brucellosis diagnosis followed by a specific course of antibiotics for brucellosis is critical for recovery. If you suspect exposure or have symptoms, seek immediate medical attention for proper testing and treatment.
>>> Read more here: Gastrointestinal Anthrax: Causes and Symptoms






